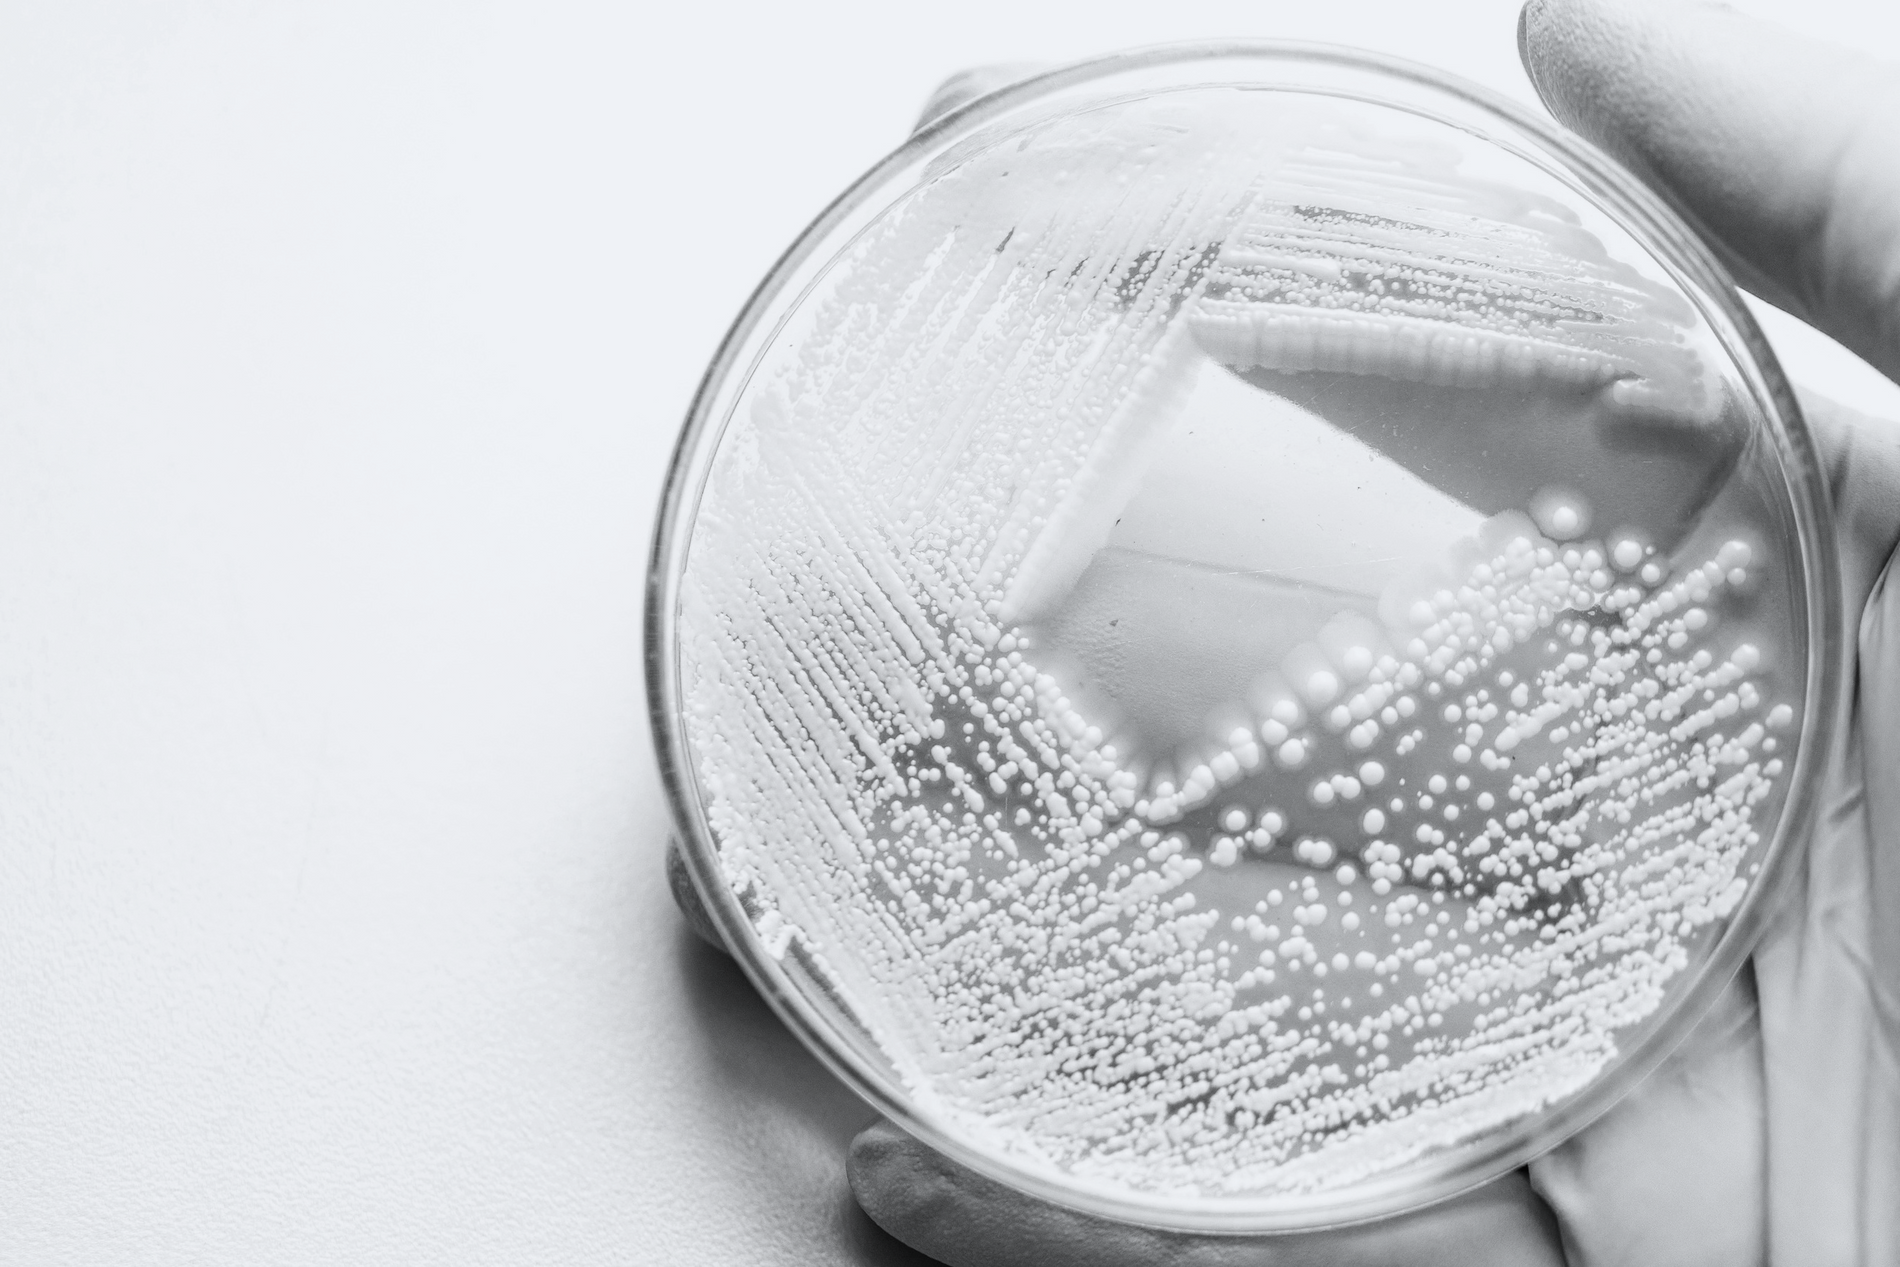

Hvad er enzymer?
Enzymer er proteiner, som findes i alle levende organismer. De fungerer som biologiske katalysatorer – dvs. de får kemiske reaktioner til at ske hurtigere, hvilket er afgørende for livets processer.
Takket være deres effektivitet og alsidighed bruges enzymer i mange brancher:
– I fødevareproduktion forbedrer de smag og tekstur
– I farmaceutisk forskning hjælper de med at fremstille lægemidler
– I rengøringsmidler nedbryder de vanskelige pletter og rester
Den samme præcision, der gør enzymer uundværlige i naturen og teknologien, gør dem nu også eftertragtede i moderne hudpleje.
8 fordele ved enzymer i hudpleje
1. Inspireret af naturen
Uden enzymer ville mange af kroppens biokemiske processer slet ikke finde sted. Laboratoriefremstillede enzymer efterligner disse naturlige processer – men uden at udtømme naturens ressourcer - kilde.
2. Milde men effektive
Fordi enzymer arbejder målrettet, er de meget hudvenlige – selv for sensitiv hud – men stadig meget virksomme - kilde.
3. Tilpasset effekt
Enzymer kan skræddersys til specifikke hudbehov. Det gør dem velegnede til forskellige hudtyper og tilstande – fra sensitiv til moden eller aknetendens - kilde.
4. Kraftig antioxidantbeskyttelse
Visse enzymer har antioxidante egenskaber, som beskytter huden mod frie radikaler og miljøpåvirkning - kilde.
5. Blid eksfoliering
Enzymer fjerner døde hudceller skånsomt – uden irritation eller mikroskader. De arbejder kun i de yderste hudlag og efterlader huden glattere og mere ensartet - kilde.
6. Forbedret fugtbalance og optagelse
Ved at fjerne døde hudceller hjælper enzymer huden med bedre at optage aktive ingredienser og holde på fugten - kilde.
7. Velegnet til alle hudtyper
Enzymer kan bruges af de fleste – også på sensitiv, tør, moden eller uren hud – takket være deres milde og balancerede virkning - kilde.
8. Mere miljøvenlige*
Sammenlignet med traditionelle ingredienser kræver enzymer markant færre ressourcer at producere:
-
Vitamin C (15%) → Enzymer (1%) bruger 30% mindre jord, udleder 80% mindre CO₂ og kræver 80% mindre fossil energi
-
AHA (30%) / BHA (2%) → Enzymer (1%) reducerer jordforbrug med 60%, CO₂ med 90% og energiforbrug med 90%
-
Planteudvundne enzymer → Laboratorie-fremstillede enzymer bruger 50% mindre jord, udleder 30% mindre CO₂ og kræver 10% mindre energi
Derudover er enzymer bionedbrydelige, efterlader ingen skadelige rester og konkurrerer ikke med fødevareproduktion om dyrkbar jord.
Effektive, sikre og bæredygtige
Enzymer skaber den perfekte balance mellem effektivitet, hudvenlighed og bæredygtighed. Deres målrettede virkning og lave miljøaftryk gør dem til et godt alternativ til klassiske ingredienser som C-vitamin og AHA/BHA-syrer.
I takt med at skønhedsbranchen bevæger sig mod mere videnskabeligt dokumenterede og bæredygtige løsninger, står enzymer frem som en af de mest lovende innovationer i moderne hudpleje.
Er du klar til at skifte til enzymbaseret hudpleje?
*Data: Bioli, juli 2024 – baseret på OpenLCA-analyse (metode: ReCiPe2016).